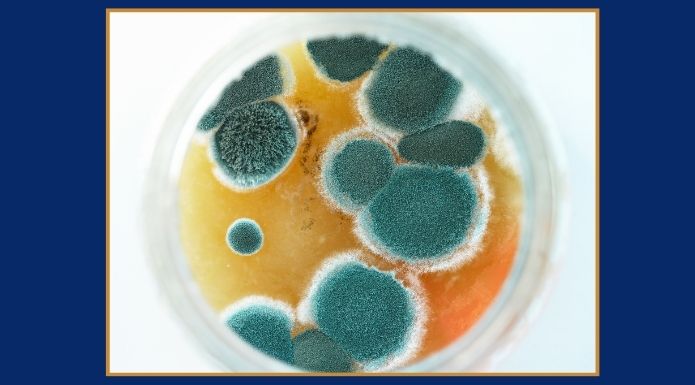

The Air Fryer Stovetop Method: Flexibility Over Presets
There is something about the air fryer that is missing from most online information. We call the it a “fryer” but treat it like an oven. An air fryer is not an oven. In fact, despite the fact that it works like a convection oven, it is also not a convection oven. We are often … Read more